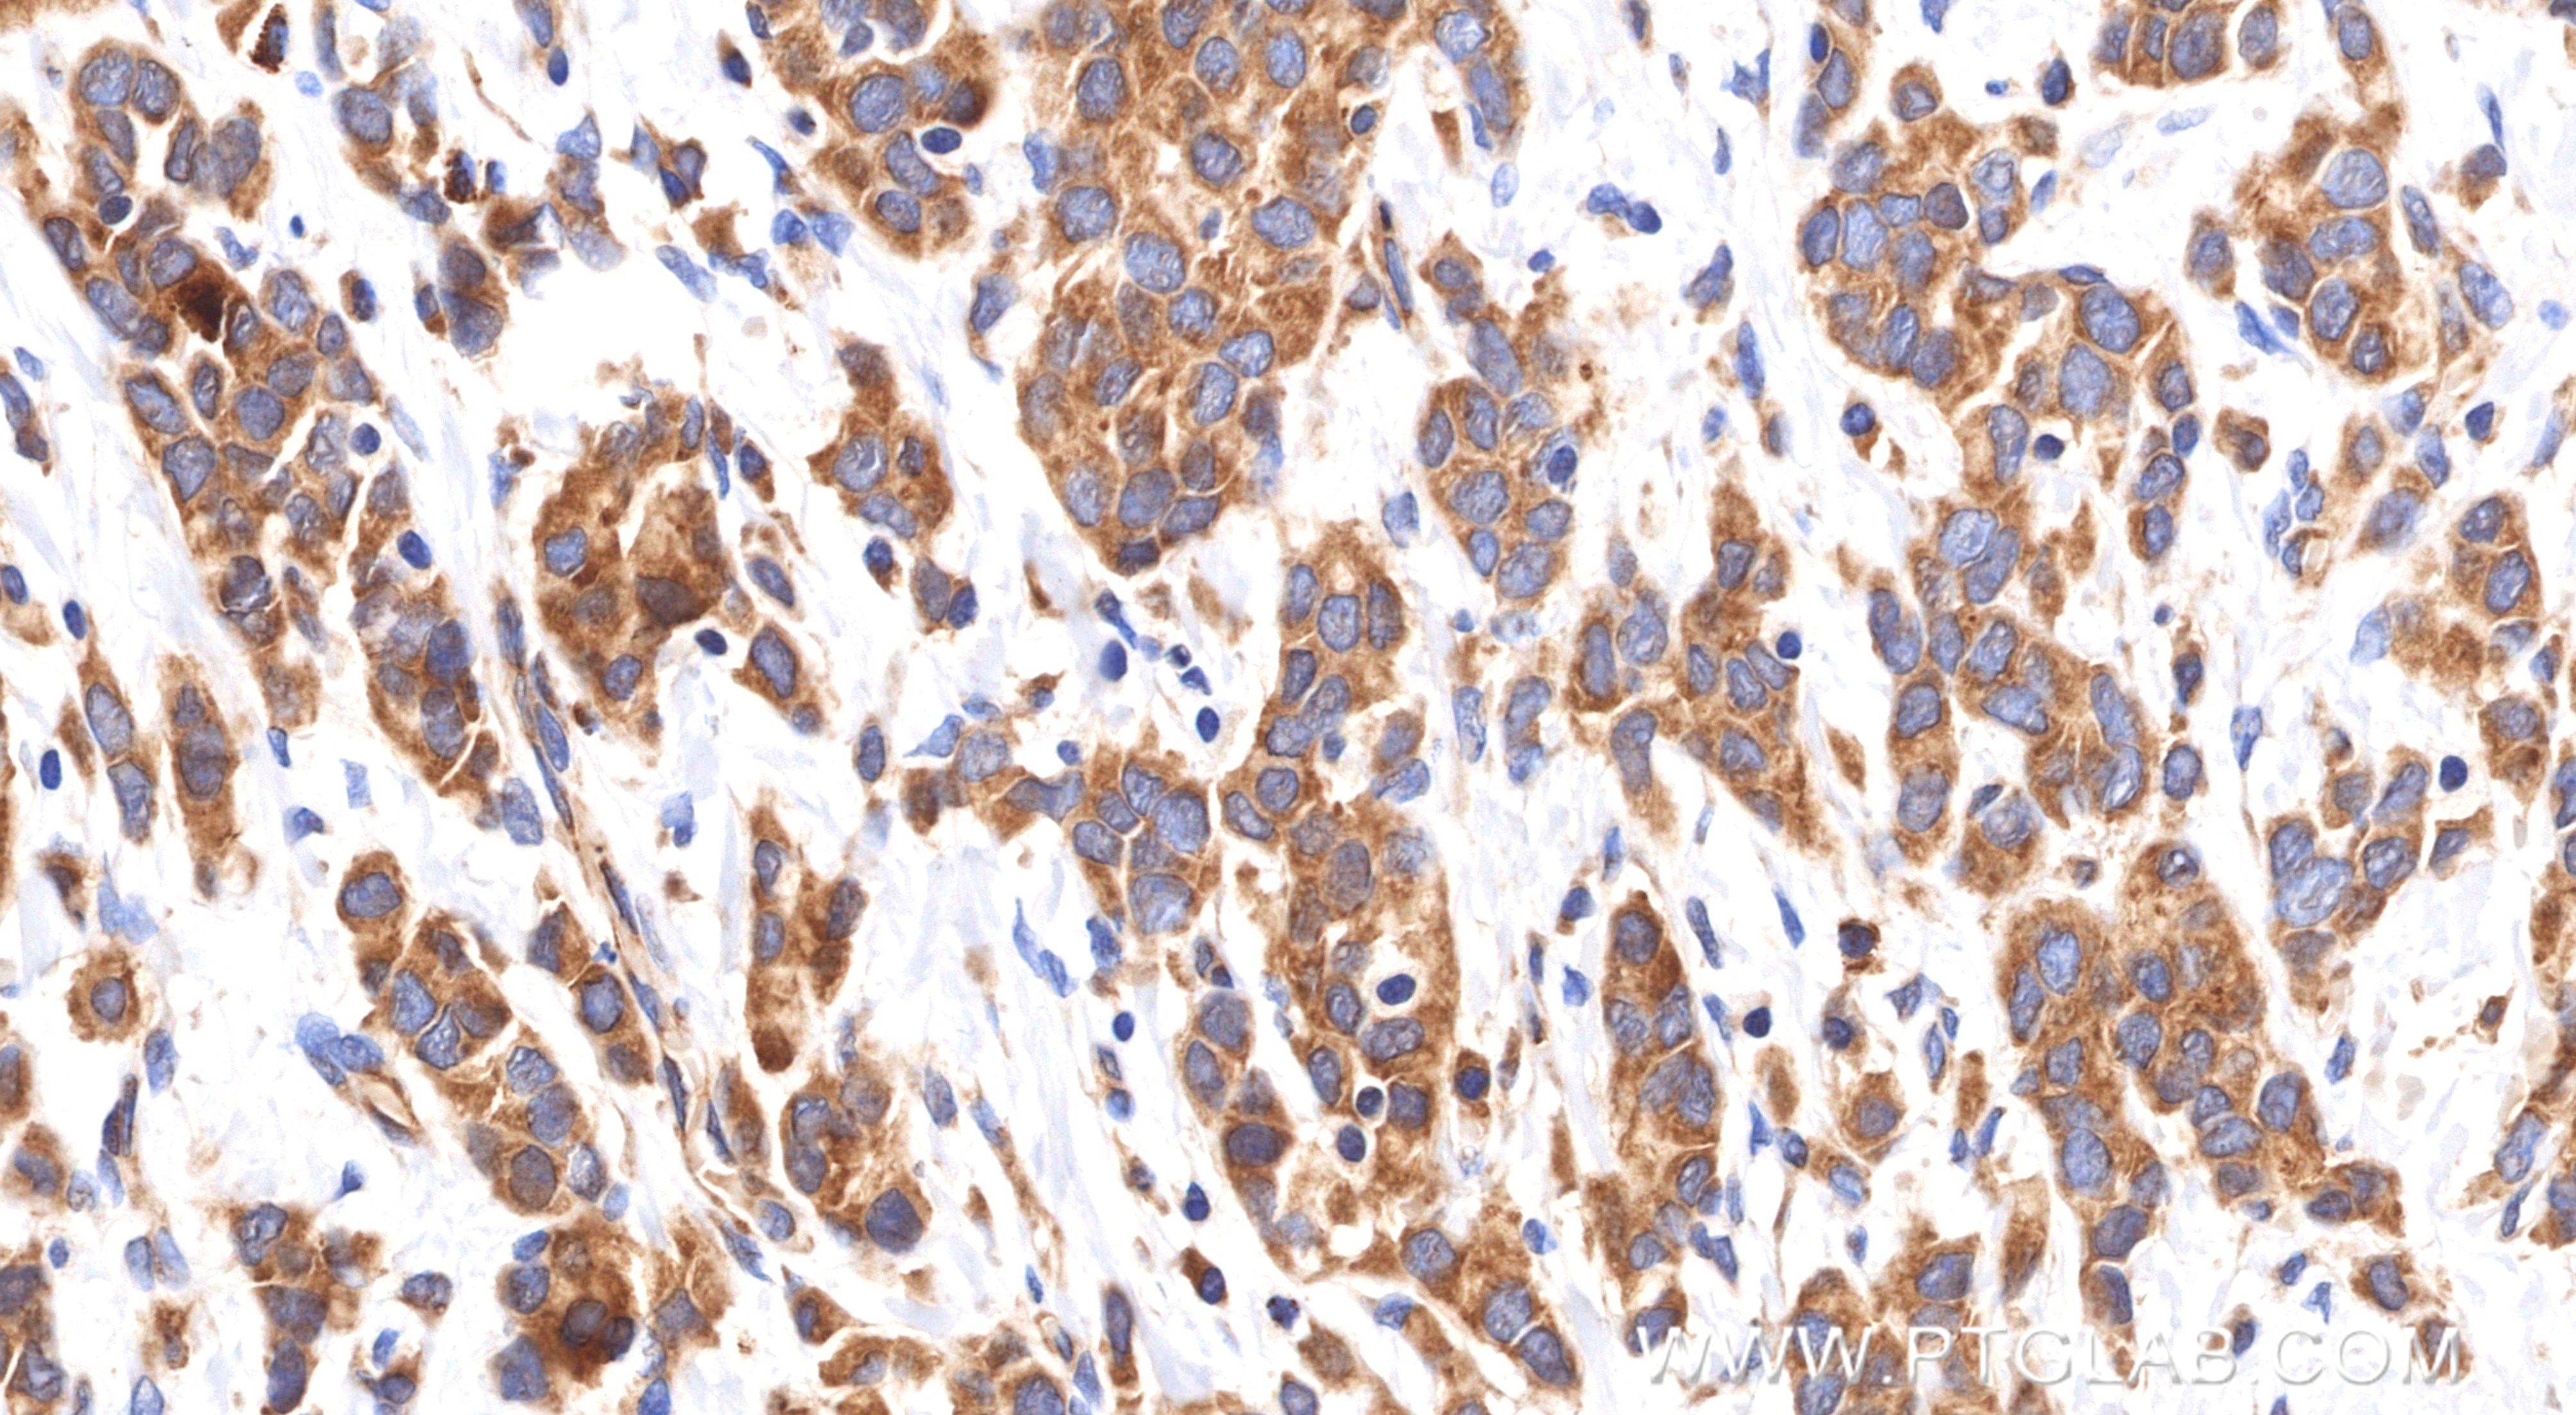
Immunohistochemistry (IHC) staining of human breast cancer tissue using EPS8 Recombinant monoclonal antibody (85184-5-RR)

Tested Applications
| Positive WB detected in | NIH/3T3 cells, C2C12 cells |
| Positive IHC detected in | human breast cancer tissue Note: suggested antigen retrieval with TE buffer pH 9.0; (*) Alternatively, antigen retrieval may be performed with citrate buffer pH 6.0 |
Recommended dilution
| Application | Dilution |
|---|---|
| Western Blot (WB) | WB : 1:5000-1:50000 |
| Immunohistochemistry (IHC) | IHC : 1:200-1:800 |
| It is recommended that this reagent should be titrated in each testing system to obtain optimal results. | |
| Sample-dependent, Check data in validation data gallery. | |
Product Information
85184-5-RR targets EPS8 in WB, IHC, ELISA applications and shows reactivity with human, mouse samples.
| Tested Reactivity | human, mouse |
| Host / Isotype | Rabbit / IgG |
| Class | Recombinant |
| Type | Antibody |
| Immunogen |
CatNo: Ag3121 Product name: Recombinant human EPS8 protein Source: e coli.-derived, PGEX-4T Tag: GST Domain: 13-267 aa of BC030010 Sequence: GMYPSQMNGYGSSPTFSQTDREHGSKTSAKALYEQRKNYARDSVSSVSDISQYRVEHLTTFVLDRKDAMITVDDGIRKLKLLDAKGKVWTQDMILQVDDRAVSLIDLESKNELENFPLNTIQHCQAVMHSCSYDSVLALVCKEPTQNKPDLHLFQCDEVKANLISEDIESAISDSKGGKQKRRPDALRMISNADPSIPPPPRAPAPAPPGTVTQVDVRSRVAAWSAWAADQGDFEKPRQYHEQEETPEMMAARID Predict reactive species |
| Full Name | epidermal growth factor receptor pathway substrate 8 |
| Calculated Molecular Weight | 822 aa, 92 kDa |
| Observed Molecular Weight | 97 kDa |
| GenBank Accession Number | BC030010 |
| Gene Symbol | EPS8 |
| Gene ID (NCBI) | 2059 |
| Conjugate | Unconjugated |
| Form | Liquid |
| Purification Method | Protein A purification |
| UNIPROT ID | Q12929 |
| Storage Buffer | PBS with 0.02% sodium azide and 50% glycerol, pH 7.3. |
| Storage Conditions | Store at -20°C. Stable for one year after shipment. Aliquoting is unnecessary for -20oC storage. 20ul sizes contain 0.1% BSA. |
Background Information
Epidermal growth factor receptor Pathway Substrate 8 (EPS8) is a crucial regulator of the actin cytoskeleton dynamics accompanying cell motility and invasion. This protein contains one PH domain and one SH3 domain leading to its binding activity with multiple cellular targets. EPS8 can function as a unique actin capping protein specifically required for dendritic cell migration and plays roles in the regulation of axonal filopodia in neuronal development and synapse formation. The EPS8 gene may contribute to the development of a subset of colorectal cancers and could have applications in diagnosis and treatment.
Protocols
| Product Specific Protocols | |
|---|---|
| IHC protocol for EPS8 antibody 85184-5-RR | Download protocol |
| WB protocol for EPS8 antibody 85184-5-RR | Download protocol |
| Standard Protocols | |
|---|---|
| Click here to view our Standard Protocols |